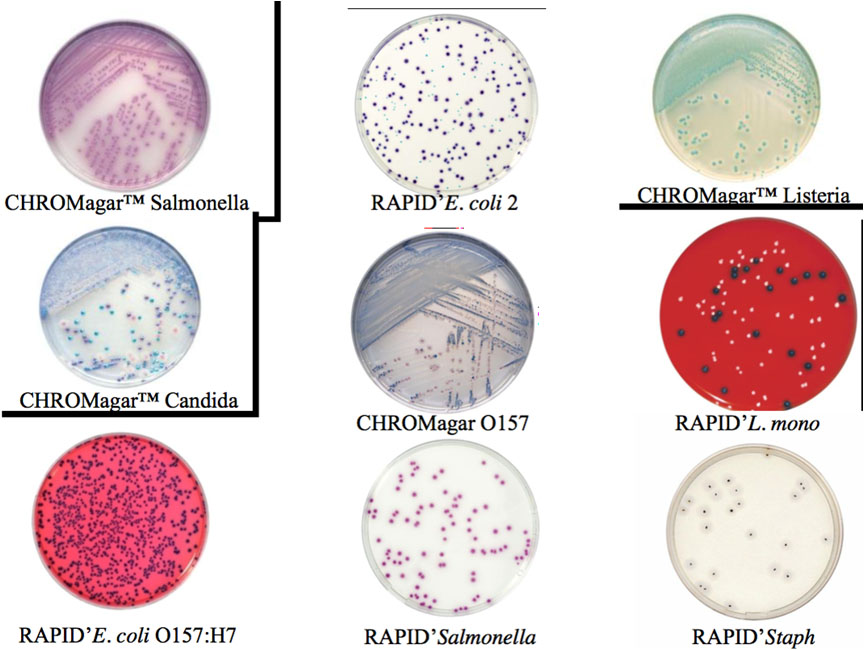
Σεμινάριο «Κίνδυνοι Υγείας στα Ξενοδοχεία»

Άρθρα

AusTreat- BMSB πιστοποιητικό για Αυστραλία 2024-2025
Τί είναι το AUSTREAT- πρώην BMSB; To AusTreat αποτελεί ένα νέο προ-συνοριακό σχέδιο εφαρμογών αποπαρασίτωσης με σκοπό την βιοασφάλεια. Αυτό σημαίνει, ότι AusTreat είναι ένα ολιστικό, ολοκληρωμένο σύστημα που έχει σχεδιαστεί για να μπορεί να...

Ασφάλεια των αποθηκευμένων σιτηρών σε 4 βήματα
Ασφάλεια των αποθηκευμένων σιτηρών σε 4 βήματα Στα πλαίσια των συνεχόμενων ερευνών, στις οποίες συνεχώς επενδύουμε στην AgroSpeCom, σας παρουσιάζουμε τα παρακάτω αποτελέσματα. Οι 3 στόχοι μας είναι: η τελειοποίηση των απεντομώσεων των πελατών μας η...

Κυκλοφορούν φίδια μέσα στο χειμώνα;
H κλιματική αλλαγή είναι πλέον εδώ. Παλαιότερα μιλούσαμε για τους επερχόμενους κινδύνους από την μελλοντική κλιματική αλλαγή, τώρα πλέον είμαστε ήδη μέσα στο πρόβλημα και βιώνουμε τις επιπτώσεις της κλιματικής αλλαγής. Οι παρατεταμένες υψηλές...

Υποτροφία Αθανασίου Σωτηρούδα με τιμή & όραμα!
Φωτογραφία από την απονομή της υποτροφίας το 2017, από τον ίδιο τον Αθανάσιο Σωτηρούδα. Από το 2014 κάθε μεταπτυχιακός φοιτητής, που εργάζεται στα έντομα αποθηκευμένων τροφίμων, έχει τη δυνατότητα να διεκδικήσει την υποτροφία «Αθανασίου Σωτηρούδα»....

Πρόγραμμα DePhosphine
Το πρόγραμμα DePhosphine δημιουργήθηκε από τη συνεργασία του εντομολογικού τμήματος του Πανεπιστημίου Θεσσαλίας, του Ιδρύματος Τεχνολογίας της Κρήτης και της AgroSpeCom. Το DePhosphine αφορά στους εναλλακτικούς ρεαλιστικούς τρόπους απεντόμωσης στην...

ISPM-15 απεντόμωση παλετών & ξυλοκιβωτίων
Τί είναι το πρωτόκολλο απεντόμωσης ISPM-15 Βάσει της διεθνoύς νομοθεσίας, όλα τα ξύλινα μέσα συσκευασίας πρέπει να φέρουν το σήμα σύμφωνα με το διεθνές πρότυπο ISPM-15 (International Standrard for Phytosanitary Measures) αφού έχουν υποστεί...

Aeright: Παρακολούθηση ποιότητας αέρα 24/7
aeright™ – Ποιοτικός Αέρας με Υποστήριξη Ai! Έχετε τον έλεγχο του αέρα που αναπνέετε; Εργάζεστε ή ζείτε σε έναν χώρο που δεν αισθάνεστε ασφαλείς για τον αέρα που αναπνέετε; Εισέρχονται πολλοί επισκέπτες/ πελάτες και νιώθετε ότι εκτίθεστε...

Aπεντόμωση κατά Khapra Beetle για εξαγωγές στην Αυστραλία
Υποχρεωτικές απεντομώσεις του Khapra Beetle (Trogoderma granarium) για εξαγωγές στην Αυστραλία Khapra Beetle Πιστοποιητικό για εξαγωγές στην Αυστραλία Το Αυστραλιανό Υπουργείο Γεωργίας ανακοίνωσε την υποχρέωση για πιστοποιητικό απεντόμωσης...

Ποιες οι αλλαγές του νέου IFS v7
Το IFS αναβαθμίστηκε από την έκδοση 6.1. στην έκδοση 7! Μετά από πολλές αναβολές λόγω της πανδημίας εκδόθηκε πλέον η νέα έκδοση IFS v.7 για την οποία η μετάβαση κρίνεται υποχρεωτική από 1/7/2021. Οι αλλαγές Σύμφωνα με τους εκδότες, το νέο IFS Food...

Γιατί πηγαίνουμε στο σχολείο;
Σε μια εποχή που οι συζητήσεις γύρω από την εκπαίδευση κατευθύνονται κυρίως γύρω από τις μάσκες, την ασφυξία που προκαλούν (!) και την απολύμανση των χώρων, το άρθρο αυτό κοιτάει τα πράγματα από την αρχή: Μπορεί η αρχή να είναι το κρυφό σχολειό...

School Fogger για αυτόνομη απολύμανση αιθουσών
School Fogger για αυτόνομη απολύμανση αιθουσών κατά του Covid-19 Αποτελεσματικότητα και σιγουριά για την ασφάλεια των μαθητών Αυτονομία στην απολύμανση χωρίς αναμονή συνεργείου Έλεγχος των εφαρμογών απολύμανσης μέσω App, από όπου και αν βρίσκεστε...

Room Fogger: Απολύμανση για Covid-19 σε Ξενοδοχεία, AirBnb, Σκάφη
H AgroSpeCom δραστηριοποιείται από το 1980 σε όλη την Ελλάδα στις Απολυμάνσεις - Απεντομώσεις - Μυοκτονίες, απασχολεί μόνο επιστήμονες και εξειδικεύεται στον κλάδο HORECA και στη Βιομηχανία τροφίμων με επώνυμο πελατολόγιο. Room Fogger για αυτόνομη...

Free Online Seminar Centaur: Απεντομώσεις Ακριβείας – 26/5 ώρα 15:00
Αγαπητοί, Έχουμε την χαρά και την τιμή να σας προσκαλέσουμε να παρακολουθήσετε το δωρεάν live webinar που διοργανώνει η αδελφή εταιρία μας Centaur με θέμα τις απεντομώσεις ακριβείας, οι οποίες εξασφαλίζουν τη μέγιστη ασφάλεια των τροφίμων και των...

Αντιμετωπίζοντας τον Covid-19. Πώς και πότε επιλέγω να κάνω απολύμανση;
Προτεινόμενα Προληπτικά και Κατασταλτικά μέτρα απολύμανσης & διαχείρισης του SARS-CoV-2 Τρόποι -Μέθοδοι αντιμετώπισης του κορωνοϊού Υπεριώδης ακτινοβολία Θέρμανση (56°C επί 15 λεπτά) Απολυμαντικά: Αιθέρας, Αιθυλική Αλκοόλη (60-75%),...

Εντατικοποίηση ελέγχων για τα Χριστούγεννα 2019 σε χώρους τροφίμων
Εγκύκλιος Δ1γ/ ΓΠ οικ.88899/2019 - Εντατικοποίηση υγειονομικών ελέγχων ενόψει Χριστουγέννων 2019 Σε ποιές επιχειρήσεις θα δοθεί προτεραιότητα και πώς θα διενεργηθούν οι υγειονομικοί έλεγχοι. Εντατικοποίηση των υγειονομικών ελέγχων ενόψει της...

Θερμική απεντόμωση BMSB για Αυστραλία 2023-2024
BMSB Θερμική απεντόμωση εμπορευμάτων με πιστοποιητικό Μετά την ανανέωση της Aυστραλιανής νομοθεσίας για το BMSB πιστοποιητικό κατά τη νέα σαιζόν 1/9/2023 έως 30/4/2024, όλες οι εξαγωγές εμπορευμάτων που προορίζονται για την Αυστραλία ή τη Νέα...

Στο διεθνές συνέδριο αποθηκευμένων προϊόντων IWCSPP στο Βερολίνο συμμετείχε η AgroSpeCom
Στα πλαίσια της συνεχόμενης εκπαίδευσης και συμμετοχής στην έρευνα, η AgroSpeCom συμμετείχε μαζί με τη Centaur στο διεθνές συνέδριο IWCSPP του Βερολίνου για την προστασία των αποθηκευμένων προϊόντων. Το έργο μας παρουσιάστηκε μέσω προφορικής...

Τα Ακάρεα που Ζουν στο Πρόσωπό Μας
Γνωρίζετε πως στο πρόσωπο του καθενός από εμάς ζουν χιλιάδες μικροσκοπικά τέρατα; Τα ακάρεα, ζουν σε μεγάλους αριθμούς παντού, ακόμα και στο πρόσωπό μας! Όσο και αν πλένουμε το πρόσωπό μας, τα μικροσκοπικά αυτά αρθρόποδα δεν πρόκειται να μας...

Απονομή της Υποτροφίας “Αθανασίου Σωτηρούδα”
Την προηγούμενη εβδομάδα, μιλήσαμε με την κα. Μαρία Σακκά, στην οποία απονεμήθηκε η υποτροφία "Αθανασίου Σωτηρούδα" για δεύτερη χρονιά και αφορά νέους εντομολόγους που αποφάσισαν να ασχοληθούν με τα έντομα αποθηκευμένων τροφίμων. Η Μαρία εκπονεί το...

Σεμινάριο ολοκληρωμένης διαχείρισης επιβλαβών ζωικών οργανισμών σε ξενοδοχεία.
Σεμινάριο για την εφαρμογή της ολοκληρωμένης διαχείρισης επιβλαβών ζωικών οργανισμών σε ξενοδοχεία, πραγματοποιήθηκε στις 13 και 14 Μαΐου 2017, στο Σούνιο. Διοργανωτές του σεμιναρίου ήταν ο Σύνδεσμος Εταιρειών Απεντομώσεων Μυοκτονιών Ελλάδος...

Η πρώτη επιθεώρηση στον κόσμο κατά GSTC
Αειφορία και Τουρισμός Η πρώτη επιθεώρηση στον κόσμο κατά GSTC είναι γεγονός και θα συμβεί εδώ, στη γειτονιά μας! Συγκεκριμένα, σε μία από τις ναυαρχίδες της τουριστικής βιομηχανίας μας, στο νησί της Ρόδου και σε έναν από τους πλέον αναγνωρίσιμους...

Global Sustainable Tourism Council (GSTC)
GSTC: Το νέο ολοκληρωμένο πρότυπο αειφορίας για ξενοδοχεία - τουριστικές επιχειρήσεις -προορισμούς Η αυξανόμενη ζήτηση για αειφόρα ξενοδοχεία έχει οδηγήσει τις επιχειρήσεις στην υιοθέτηση και πιστοποίηση αειφόρων πρακτικών με ιδιωτικά...

Ιδού το σεμινάριο Ρόδου
αρχείο[/su_button] [su_quote]ΙΔΟΥ Η ΡΟΔΟΣ, ΙΔΟΥ ΚΑΙ ΤΟ ΠΗΔΗΜΑ Η παροιμιώδης αυτή έκφραση, προέρχεται από τον μύθο του Αισώπου, «Ανήρ κομπαστής», και χρησιμοποιείται για όσους καυχιούνται για κάτι και το υποστηρίζουν, αλλά αδυνατούν να αποδείξουν τα...

Σεμινάριο “Διαχείριση Υγείας & Ενέργειας στα Ξενοδοχεία”
Η Agrospecom και ο Σύλλογος Διευθυντών Ξενοδοχείων Ρόδου διοργανώνουν το σεμινάριο "Διαχείριση Υγείας & Ενέργειας στα Ξενοδοχεία" στο ξενοδοχείο Best Western Plaza, στη Ρόδο, την Τετάρτη 29 Μαρτίου 2017. Το πρόγραμμα και η αίτηση συμμετοχής ...

Υποτροφία “Αθανάσιου Σωτηρούδα”
Για δεύτερη συνεχή χρονιά η Agrospecom χορηγεί την υποτροφία "Αθανάσιος Σωτηρούδας". Σας παραθέτουμε το άρθρο(φωτό) από το ενημερωτικό δελτίο της Εντομολογικής Εταιρείας Ελλάδος. Θα ακολουθήσει ενημέρωση σχετικά, μετά την επίσημη τελετή...

Έκθεση Βιολογικών Προιόντων Biofach.
Η AgroSpeCom - Control Union Greece συμμετέχει στην Έκθεση Βιολογικών Προιόντων Biofach. Η έκθεση ανοίγει τις πύλες στην Νυρεμβέργη από 15 ως 18 Φεβρουαρίου και φιλοξενεί 2,811 εκθέτες! Ένας από αυτούς είναι και η Control Union. Μπορείτε να μας...

Η κοπή της βασιλόπιτας 2017
Η κοπή της βασιλόπιτας της AgroSpeCom έλαβε χώρα στις 26 Ιανουαρίου 2017. Ήταν μια ευκαιρία να συναντηθουν περισσότεροι από 20 συνεργάτες από τα 5 γραφεία της Ελλάδας. Επιπλέον μας τίμησαν με την παρουσία τους οι: Δρ. Χριστος Αθανασίου από το...

Η AgroSpeCom στηρίζει την βελτίωση της υγιεινής στους καταυλισμούς προσφύγων.
Στις αρχές Δεκεμβρίου 2016 η AgroSpeCom / Control Union Ελλάδας εφάρμοσε την τεχνική της Θερμικής Απεντόμωσης σε μια προσωρινή κατοικία για πρόσφυγες στη Βόρεια Ελλάδα. Περισσότεροι από 1,5 εκατομμύρια πρόσφυγες πέρασαν στην Ευρώπη από τις αρχές...

Συνεργασία AgroSpeCom με το LIFE CONOPS
H AgroSpeCom σε συνεργασία με το Μπενάκειο Φυτοπαθολογικό Ινστιτούτο συμμετέχει το 2016 στο πρόγραμμα “LIFE CONOPS” (LIFE12 ENV/GR/000466). Το εν λόγω πρόγραμμα συγχρηματοδοτείται κατά 50% από το Ευρωπαϊκό πρόγραμμα LIFE+ Environment Policy and...

Ένα από τα πιο εντυπωσιακά έντομα του πλανήτη. (Trachelophorus gerefa)
Πολλά είναι τα είδη των εντόμων που μας ενθουσιάζουν με την παράξενη εμφάνισή τους. Το Trachelophorus giraffe είναι ένα από αυτά. Θα μπορούσε κανείς να πει πως είναι ένα από τα εντυπωσιακότερα έντομα του πλανήτη. Είναι ενδημικό είδος της...

Τριατομίνες, κανένας λόγος ανησυχίας για την Ελλάδα.
Πολύς λόγος γίνεται τελευταία για τις Τριατομίνες, έντομα που σύμφωνα με αυτούς που διαδίδουν αυτές τις πληροφορίες στα μέσα κοινωνικής δικτύωσης, είναι πολύ επικίνδυνα για τη ζωή του ανθρώπου και στην Ελλάδα! Ποια όμως είναι η αλήθεια για τις...

Julodis Sp.
Το Julodis Sp είναι κολεόπτερο της υπεροικογενείας των Buprestoidea, της οικογενείας των Buprestidae. Τα είδη του γένους Julodis μπορούμε να τα χωρίσουμε σε δύο κατηγορίες σύμφωνα με την γεωγραφική τους εξάπλωση, τα άτομα που ζουν στη Νότια...

Diplopoda
Τα Diplopoda είναι αρθρόποδα που ανήκουν στην μεγαλύτερη Τάξη της Κλάσης των Μυριαπόδων ( Myriapoda), με περισσότερα από 12,000 είδη. Λέγονται Διπλόποδα διότι από τους περισσότερους θωρακικούς και κοιλιακούς δακτυλίους βγαίνουν δύο πόδια. Το πιο...

Η παρουσίαση του Βασίλη Σωτηρούδα στο Cashew World Conference
Ο Βασίλης Σωτηρούδας, διευθυντής της AgroSpeCom έκανε την παρουσίαση με θέμα «Έξυπνες Απεντομώσεις» στο Cashew World Conference στο Ντουμπάι, στις 18-20 Φεβρουαρίου 2016. Η παρουσίαση από το συνέδριο εδώ. Περισσότερες πληροφορίες για...
Σεμινάριο «Κίνδυνοι Υγείας στα Ξενοδοχεία»
Η AgroSpeCom διοργανώνει το σεμινάριο «Κίνδυνοι Υγείας στα Ξενοδοχεία» στο hotel Park, στο Βόλο, τη Δευτέρα 16 Μαΐου 2016. Πρόκειται για ένα εξειδικευμένο σεμινάριο υψηλής ποιότητας για τα προβλήματα υγιεινής στα ξενοδοχεία, την πρόληψη και τη...

Σεμινάριο «Κίνδυνοι Υγείας στα Ξενοδοχεία»
Η AgroSpeCom διοργανώνει το σεμινάριο «Κίνδυνοι Υγείας στα Ξενοδοχεία» στο hotel Plaza, στη Ρόδο, την Τρίτη 5 Απριλίου 2016. Πρόκειται για ένα εξειδικευμένο σεμινάριο υψηλής ποιότητας για τα προβλήματα υγιεινής στα ξενοδοχεία, την πρόληψη και τη...

Ελληνική Εντομολογική Εταιρεία: Υποτροφία Αθανάσιος Σωτηρούδας
Απονεμήθηκε η υποτροφία Αθανάσιος Σωτηρούδας 2015-2016 της Ελληνικής Εντομολογικής Εταιρείας (ΕΕΕ) σε εκδήλωση που έλαβε χώρα κατά τη διάρκεια της έκθεσης Agrotica Helexpo - ΔΕΘ το Σάββατο 30 Ιανουαρίου 2016. Την απονομή πραγματοποίησε ο ίδιος ο...

Στρογγυλή Τράπεζα: «Η πιστοποίηση του επαγγελματία διαχείρισης επιβλαβών οργανισμών»
Η διεξαγωγή της Ημερίδας στις 4 Απριλίου στο χώρο του Ινστιτούτου Γεωπονικών Επιστημών (Ι.Γ.Ε.) με θέμα «Η εκπαίδευση στις απεντομώσεις» (http://www.pestpractice.eu/) οδήγησε στην ανάγκη διοργάνωσης συνάντησης μεταξύ των εμπλεκόμενων φορέων...

Τεχνολογία τροφίμων. Για άψογα τρόφιμα.
https://www.youtube.com/watch?v=PlwRiP94eTs Πώς μένει η μπριζόλα σας υπέροχη; Πώς παραμένει ο χυμός της πορτοκαλάδας σας απολαυστικός για μέρες; Η τεχνολογία τροφίμων διατηρεί τα τρόφιμά μας λαχταριστά και μας βοηθά να παραμένουμε υγιείς ενώ το...

Προκήρυξη Υποτροφίας “Αθανασίου Σωτηρούδα” 2015-2016
Χορήγηση μιας (1) υποτροφίας μεταπτυχιακών σπουδών «Αθανασίου Σωτηρούδα» από την Εντομολογική Εταιρεία Ελλάδος για το ακαδημαϊκό έτος 2015-2016 Η Εντομολογική Εταιρεία Ελλάδος προκηρύσσει πρόγραμμα χορηγήσεως υποτροφιών σε υποψηφίους για...

Σχέδιο κειμένου προς διαβούλευση για τον Οδηγό Ορθής Πρακτικής κατά τις μυοκτονίες και απεντομώσεις επιχειρήσεων.
Σχέδιο κειμένου προς διαβούλευση για τον Οδηγό Ορθής Πρακτικής κατά τις μυοκτονίες και απεντομώσεις επιχειρήσεων. Δίνεται προς διαβούλευση ο παραπάνω οδηγός έως τις 18-09-2015. Παρακαλούμε για την αποστολή των σχολίων και των παρατηρήσεων σας στα...

Στατιστικός Έλεγχος Διεργασιών
Στο τεύχος Δεκεμβρίου 2013 του περιοδικού "Τρόφιμα και Ποτά", δημοσιεύθηκε το άρθρο "Στατιστικός Έλεγχος Διεργασιών" του κ.Στέφανου Κιρκαγασλή. Ο Στατιστικός Έλεγχος Διεργασιών αναπτύχθηκε αρχικά στην Motorola το 1981 και, στη συνέχεια, στην...

Επιθεωρώντας ένα Κύκλωμα Παστερίωσης Γάλακτος
Στην ετήσια έκδοση ΓΑΛΑΚΤΟΚΟΜΙΑ 2013 φιλοξενήθηκε άρθρο του κ.Στέφανου Κιρκαγασλή με θέμα "Επιθεωρώντας ένα Κύκλωμα Παστερίωσης Γάλακτος". Σχετικά αρχεία...

Υποτροφία “Αθανάσιος Σωτηρούδας”
Σε συνεδρίαση της Ελληνικής Εντομολογικής Εταιρείας που έγινε στις 27 Ιανουαρίου 2014, συζητήθηκε η προκύρηξη υποτροφιών μεταπτυχιακών σπουδών "Αθανάσιου Σωτηρούδα", καθώς και οι προϋποθέσεις, τα κριτήρια και η διαδικασία επιλογής των υποψηφίων....

Β.Σωτηρούδας: Ομιλητής στο 11th Fumigants & Pheromones Conference
Το 11o Συνέδριο Fumigants & Pheromones θα πραγματοποιηθεί στην Κρακοβία, στις 2-4 Ιουνίου 2014. Το συνέδριο διοργανώνει η Insects Limited, Inc και θα εστιάσει σε τρέχοντα ζητήματα του μετα-συλλεκτικού Pest Management. Μεταξύ των διακεκριμένων...

Συνέδριο στην Κύπρο για τις “Νέες Εξελίξεις στη Διαχείριση Εντόμων και Τρωκτικών”
Στις 18 Μαρτίου 2014 διοργανώθηκε στην Κύπρο η Ημερίδα με θέμα "Νέες Εξελίξεις σε Θέματα Διαχείρισης Εντόμων και Τρωκτικών". Την Ημερίδα διοργάνωσαν από κοινού ο Ελληνικός και ο Κυπριακός Σύνδεσμος Πρόληψης/Καταπολέμησης Εντόμων και Τρωκτικών, ενώ...

Σεμινάριο 03/04/2014: Προβλήματα Υγιεινής στα Ξενοδοχεία
Η AgroSpeCom σας προσκαλεί σε ένα εξειδικευμένο σεμινάριο υψηλής ποιότητας για τα προβλήματα υγιεινής στα ξενοδοχεία, την πρόληψη και τη διαχείρισή τους. Το σεμινάριο θα πραγματοποιηθεί την Πέμπτη 3 Απριλίου 2014, στο Mediterranean Hotel της...
Χρηματοδότηση της AgroSpeCom από το Ε.Π. Ψηφιακή Σύγκλιση για Τεχνολογία Θερμικής Απεντόμωσης
Η AgroSpeCom λαμβάνει χρηματοδότηση από την ΚτΠ Α.Ε., και συγκεκριμένα από το πρόγραμμα ICT4Growth του Επιχειρησιακού Προγράμματος Ψηφιακή Σύγκλιση, για την ανάπτυξη καινοτόμου εφαρμογής cloud για θερμικές απεντομώσεις. Το Έργο ENTTOSOFT της...

Υποτροφία “Αθανάσιος Σωτηρούδας”
Σε συνεδρίαση της Ελληνικής Εντομολογικής Εταιρείας που έγινε στις 27 Ιανουαρίου 2014, συζητήθηκε η προκύρηξη υποτροφιών μεταπτυχιακών σπουδών "Αθανάσιου Σωτηρούδα", καθώς και οι προϋποθέσεις, τα κριτήρια και η διαδικασία επιλογής των υποψηφίων....




